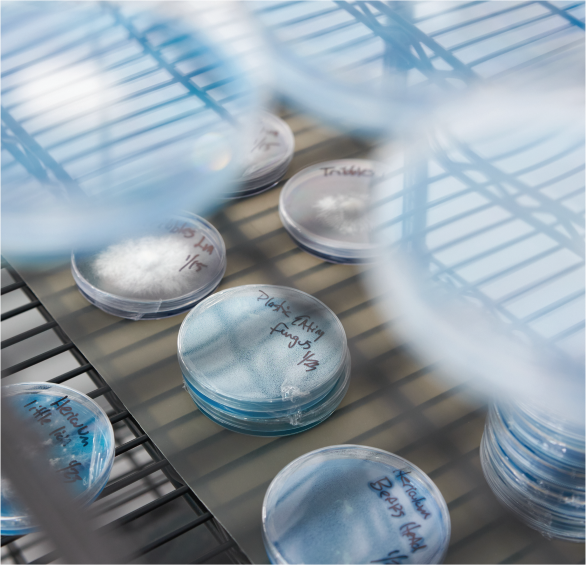

Are all Mycelium products organic?
As part of our commitment to sustainability and organic practices, all of our substrates, grains, and dry feeds are made with OMRI certified ingredients.
The Organic Materials Review Institute (OMRI) supports organic integrity by offering clear guidance on materials approved for use in certified organic production. OMRI ensures that the materials used in our products meet the strict standards required for organic operations, while also providing valuable technical support and training for professionals in the organic industry.
QUALITY CONTROL
Assurance Protocols
At Mycelium, we understand that clean and healthy grain spawn and substrates are essential for successful mushroom cultivation. That's why we meticulously manage every stage of our process—from product development and production to testing and fulfillment. Our vertically integrated approach, spanning liquid culture work through to grain spawn and substrate production, guarantees a superior product. Our experienced mycologists stay up to date on latest best practices, while our dedicated Quality Assurance and Quality Control (QAQC) team rigorously tests every batch of grain and substrate before inoculation.
Our state-of-the-art mycology laboratory, located in Garden Grove, California is part of our expansive 10,000 sq. feet production and fulfillment facility. We have designed our labs to meet the highest standards in cleanroom infrastructure and processes. Our HEPA-filtered air system ensures continuous air scrubbing and positive pressure within the rooms.
Our facility includes a culture laboratory and a cleanroom built to ISO 7 standards, with 90 air changes per hour.
Lab staff wear Tyvek suits, gloves, head and face coverings, and work within laminar flow hoods.
Monthly particle counts are conducted to verify the effectiveness of our air systems.
Weekly testing of flow hoods using particle counters and settle plates ensures their proper function.
Produced in a dedicated lab space and inoculated under laminar flow by trained personnel.
Every three months, new plates are made from our freezer stock. Cultures are stored in a −80°C freezer in glycerol, a cryoprotectant that prevents ice crystal formation and cell damage.
Bioindicators are used to monitor the autoclaving process, and our quality control department oversees these procedures.
All sterilized substrates are tested post-autoclaving for bacterial presence.
Product batches are evaluated for optimal pH and moisture content.
With these comprehensive protocols, we ensure that every product meets the highest standards of quality and reliability.
We understand that human error is one of the leading causes of contamination, which is why we go above and beyond with rigorous training in sterile techniques and hold our lab team to the highest standards. Our commitment is to a clean, contamination-free environment, upheld by a team of experts.